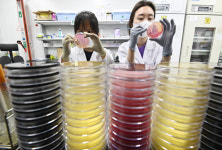

남원시청(집단급식소) 총121명이 열람하였으며, 0개의 리뷰가 있습니다.
- 시설명
- 남원시청(집단급식소)
- 시도명
- 전북특별자치도
- 시군구명
- 남원시
- 소재지도로명주소
- 전북특별자치도 남원시 시청로 60
- 시설구분명
- 집단급식소
- 담당기관명
- 남원시보건소
- 담당부서명
- 건강생활과
- 담당부서전화번호
- 063-620-7933
- 데이터기준일자
- 2024-11-25
- 제공기관코드
- 4,701,000
- 제공기관명
- 전북특별자치도 남원시
주변 목록
남원시청
전북특별자치도 남원시 시청로 60 (도통동)
'남원시청(집단급식소)'에서 0km
전북특별자치도 남원시 시청로 60 (도통동)
바로가기
남원영어체험학습센터
전북특별자치도 남원시 시청북로 29
'남원시청(집단급식소)'에서 0.2km
전북특별자치도 남원시 시청북로 29
바로가기
우와모텔
전북특별자치도 남원시 옥정5길 12-12
'남원시청(집단급식소)'에서 0.3km
전북특별자치도 남원시 옥정5길 12-12
바로가기
24시녹주사우나
전북특별자치도 남원시 농고길 13 (도통동)
'남원시청(집단급식소)'에서 0.3km
전북특별자치도 남원시 농고길 13 (도통동)
바로가기
용성고등학교
전북특별자치도 남원시 농고길 41 (도통동)
'남원시청(집단급식소)'에서 0.3km
전북특별자치도 남원시 농고길 41 (도통동)
바로가기
용성고등학교(집단급식소)
전북특별자치도 남원시 농고길 41
'남원시청(집단급식소)'에서 0.3km
전북특별자치도 남원시 농고길 41
바로가기
한국전력
전북특별자치도 남원시 충정로 119 (향교동)
'남원시청(집단급식소)'에서 0.3km
전북특별자치도 남원시 충정로 119 (향교동)
바로가기
3&4호텔
인천광역시 미추홀구 경인로435번길 7-30 (주안동)
'남원시청(집단급식소)'에서 235.6km
인천광역시 미추홀구 경인로435번길 7-30 (주안동)
바로가기
주변 관광 음식점
클럽볼륨
전북특별자치도 무주군 설천면 심곡리 1209-22 중앙상가 A-5동 2-26
'남원시청(집단급식소)'에서 61.47km
바로가기
레드카
대구광역시 동구 신천동 314-3
'남원시청(집단급식소)'에서 122.72km
바로가기
스카이슈퍼돔관광나이트클럽
충청남도 천안시 서북구 불당동 684-1번지
'남원시청(집단급식소)'에서 157.2km
바로가기
슈퍼스타마마
울산광역시 남구 삼산동 1564-11번지 2층
'남원시청(집단급식소)'에서 177.21km
바로가기
자유의 여신
경기도 수원시 팔달구 인계동 1133-8
'남원시청(집단급식소)'에서 207.31km
바로가기
라운딩
제주특별자치도 제주시 연동 262-14
'남원시청(집단급식소)'에서 229.96km
바로가기
뮤직&바
강원특별자치도 고성군 토성면 신평리 202-15
'남원시청(집단급식소)'에서 330.5km
바로가기
주변 관광 펜션
라온풀빌라 B동
충청남도 예산군 덕산면 신평리 117-9
'남원시청(집단급식소)'에서 6617.43km
바로가기
더큐브하우스리조트
충청남도 태안군 원북면 청산리
'남원시청(집단급식소)'에서 6617.43km
바로가기
(주)케이씨티
충청남도 보령시 남포면 월전리 산 154-1 102동
'남원시청(집단급식소)'에서 6617.43km
바로가기
빌라 마르디
충청북도 단양군 영춘면 상리 600-11
'남원시청(집단급식소)'에서 6617.43km
바로가기
(주)한네트
충청남도 보령시 남포면 월전리 산 154-1번지
'남원시청(집단급식소)'에서 6617.43km
바로가기
한국컴퓨터(주)
충청남도 보령시 남포면 월전리 산 154-1번지 101, 204동
'남원시청(집단급식소)'에서 6617.43km
바로가기
(주)하이원추추파크
강원특별자치도 삼척시 도계읍 심포리 231-3
'남원시청(집단급식소)'에서 6617.43km
바로가기
콩매아
충청남도 청양군 대치면 광대리 270-3
'남원시청(집단급식소)'에서 6617.43km
바로가기
(주)한국문학사
충청남도 보령시 남포면 월전리 산 154-1번지 205동
'남원시청(집단급식소)'에서 6617.43km
바로가기
(주)한상개발
충청남도 보령시 남포면 월전리 산 154-1번지 206동
'남원시청(집단급식소)'에서 6617.43km
바로가기
라온풀빌라4호
충청남도 예산군 덕산면 신평리 117-11
'남원시청(집단급식소)'에서 6617.43km
바로가기
라온풀빌라 D동
충청남도 예산군 덕산면 신평리 117-12
'남원시청(집단급식소)'에서 6617.43km
바로가기
주변 관광지
만인의총
전북특별자치도 남원시 만인로 3
'남원시청(집단급식소)'에서 1.26km
바로가기
남원관광지
전북특별자치도 남원시 양림길 12
'남원시청(집단급식소)'에서 1.6km
바로가기
춘향테마파크
전북특별자치도 남원시 양림길 14-9
'남원시청(집단급식소)'에서 1.69km
바로가기
남원항공우주천문대
전북특별자치도 남원시 양림길 48-63
'남원시청(집단급식소)'에서 1.93km
바로가기
남원시립김병종미술관
전북특별자치도 남원시 함파우길 65-14
'남원시청(집단급식소)'에서 1.97km
바로가기
아담원
전북특별자치도 남원시 이백면 목가길 193
'남원시청(집단급식소)'에서 8.28km
바로가기
혼불문학관
전북특별자치도 남원시 사매면 노봉안길 52
'남원시청(집단급식소)'에서 9.61km
바로가기
남원백두대간생태교육장전시관
전북특별자치도 남원시 운봉읍 운봉로 151
'남원시청(집단급식소)'에서 10.86km
바로가기
지리산 온천관광지
전라남도 구례군 산동면 지리산온천로 261
'남원시청(집단급식소)'에서 12.49km
바로가기
지리산허브밸리
전북특별자치도 남원시 운봉읍 바래봉길 214
'남원시청(집단급식소)'에서 14.49km
바로가기
안개 농촌체험 휴양마을
전라남도 곡성군 고달면 고산로 39-18
'남원시청(집단급식소)'에서 14.67km
바로가기
대신주말농장 정보화마을
전라남도 곡성군 곡성읍 신리길 24-1
'남원시청(집단급식소)'에서 14.8km
바로가기
주변 관광지 숙소
산리지호텔
전북특별자치도 남원시 신촌동 437
'남원시청(집단급식소)'에서 1.1km
바로가기
지리산하이츠콘도
전북특별자치도 남원시 산곡동 15-2 중앙하이츠콘도
'남원시청(집단급식소)'에서 1.57km
바로가기
이랜드파크 켄싱턴리조트 지리산남원
전북특별자치도 남원시 어현동 37-122
'남원시청(집단급식소)'에서 1.66km
바로가기
(주)교원프라퍼티 스위트호텔남원
전북특별자치도 남원시 주천면 용담리 386-2
'남원시청(집단급식소)'에서 2.47km
바로가기
코리아에프앤씨 호스텔
전북특별자치도 남원시 신정동 919
'남원시청(집단급식소)'에서 2.67km
바로가기
더케이호텔앤리조트(주) 지리산가족호텔
전라남도 구례군 산동면 대평리 729 지리산가족호텔
'남원시청(집단급식소)'에서 12.38km
바로가기
주식회사오헤브데이호텔
전북특별자치도 남원시 운봉읍 용산리 268-14
'남원시청(집단급식소)'에서 14.33km
바로가기
구례 지리산 리조트
전라남도 구례군 광의면 수월리 58-2
'남원시청(집단급식소)'에서 20.25km
바로가기
지리산 토비스 콘도
전북특별자치도 남원시 산내면 장항리 221 지리산토비스콘도미니엄
'남원시청(집단급식소)'에서 20.57km
바로가기
일성지리산콘도미니엄
전북특별자치도 남원시 산내면 대정리 805-1 일성지리산콘도미니엄
'남원시청(집단급식소)'에서 20.9km
바로가기
스테이지리산아침
전라남도 구례군 마산면 마산리 447-5
'남원시청(집단급식소)'에서 22.73km
바로가기
웰니스 호텔 인산가
경상남도 함양군 함양읍 죽림리 1048-2
'남원시청(집단급식소)'에서 25.19km
바로가기
주변 모범음식점
인산인해
전북특별자치도 남원시 시청동로 26 (도통동)
'남원시청(집단급식소)'에서 0.13km
바로가기
풍년칼국수
전북특별자치도 남원시 시청동로 25 (도통동)
'남원시청(집단급식소)'에서 0.13km
바로가기
남원고을
전북특별자치도 남원시 시청남로 22 (도통동)
'남원시청(집단급식소)'에서 0.15km
바로가기
두거리우신탕(남원점)
전북특별자치도 남원시 옥정1길 132 (향교동)
'남원시청(집단급식소)'에서 0.15km
바로가기
신의주 찹쌀순대
전북특별자치도 남원시 시청로 47 (향교동)
'남원시청(집단급식소)'에서 0.19km
바로가기
무진장아구복
전북특별자치도 남원시 옥정5길 11 (향교동)
'남원시청(집단급식소)'에서 0.2km
바로가기
춘향골아구타운
전북특별자치도 남원시 농고길 15, 1층 (도통동)
'남원시청(집단급식소)'에서 0.25km
바로가기
새만금
전북특별자치도 남원시 시청로 39 (향교동)
'남원시청(집단급식소)'에서 0.26km
바로가기
참치사랑
전북특별자치도 남원시 시청로 39 (향교동)
'남원시청(집단급식소)'에서 0.26km
바로가기
어사정식당
전북특별자치도 남원시 시청동로 11-15 (도통동)
'남원시청(집단급식소)'에서 0.27km
바로가기
우소보소
전북특별자치도 남원시 옥정4길 11-2 (향교동)
'남원시청(집단급식소)'에서 0.28km
바로가기
오유민동태마을
전북특별자치도 남원시 시청남로 43 (도통동)
'남원시청(집단급식소)'에서 0.32km
바로가기
블로그 리뷰
-
한편, 앞서 이날 김춘진 사장은 전북 남원시청(시장 최경식)과 장수군청(군수 최훈식)에 방문하여... 학교·유치원 집단급식소와 식재료 공급업체 등을 대상으로 합동점검을 한다고 밝혔다. 주요 점검...
푸드투데이 '식품산업경제 미디어'(20240229)

일별 방문 통계
월별 방문 통계
카카오맵 바로가기
카카오맵 위치 기준 길안내
리뷰 (0)
등록된 리뷰가 없습니다.
관련 지도 선택 및 번역
첨부파일